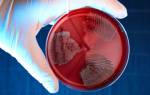

Для чего нужны промывания?
Ирригация носовой полости — это процедура, широко используемая в традиционной и альтернативной медицине для лечения воспалений в носоглотке и околоносовых пазухах. Регулярное применение физиологических растворов для обработки мерцательного эпителия укрепляет местный иммунитет. Снижение активности патогенной флоры способствует детоксикации пораженных тканей и ускоряет восстановление.
Орошение носоглотки применяется как для лечения, так и для профилактики простудных заболеваний благодаря следующим эффектам:
- очищает носовые проходы от остатков тканей, гнойного экссудата и вязкой слизи;
- снижает проницаемость сосудов, что помогает устранить отечность в носоглотке;
- дезинфицирует воспаленные ткани, уничтожая патогенные микроорганизмы;
- усиливает местный иммунитет, снижая риск повторного инфицирования ЛОР-органов;
- обеспечивает нормальную проходимость носовых путей, облегчая течение простудного заболевания.
Важно! Перед проведением ирригации носоглотки у маленьких детей обязательно проконсультируйтесь с врачом. Полипы или аномалии в строении носовой перегородки могут привести к попаданию лекарства в легкие.
Врачи отмечают, что промывание носа ребенку в домашних условиях может быть эффективным способом облегчения симптомов простуды и аллергии. Процедура помогает удалить слизь, аллергены и патогенные микроорганизмы, что способствует улучшению дыхания и снижению воспаления. Специалисты рекомендуют использовать физиологический раствор или специальные аптечные препараты, предназначенные для детей. Важно соблюдать правильную технику промывания, чтобы избежать дискомфорта и травмирования слизистой оболочки. Врачи также подчеркивают, что перед началом процедуры стоит проконсультироваться с педиатром, особенно если у ребенка есть хронические заболевания или другие медицинские показания. Правильный подход к промыванию носа может значительно улучшить состояние ребенка и ускорить процесс выздоровления.

Показания и противопоказания
Орошение носа — важная часть местной терапии для лечения как осложненных, так и неосложненных простудных заболеваний. Эта процедура помогает восстановить нормальную микрофлору в ЛОР-органах и ускоряет выздоровление. Орошение носоглотки рекомендуется при следующих состояниях:
- грипп;
- гайморит;
- фронтит;
- синусит;
- ларинготрахеит;
- аллергический ринит;
- вазомоторный ринит.
Начинать местное лечение простудных заболеваний лучше при первых признаках насморка. Устранение болезнетворных микроорганизмов в очагах воспаления помогает предотвратить дальнейшее распространение катаральных процессов.
Ирригация носа повышает эффективность медикаментов, однако следует избегать процедуры при склонности к носовым кровотечениям, остром среднем отите и непроходимости носовых проходов. Игнорирование этих противопоказаний может привести к серьезным осложнениям.
| Возраст ребенка | Способ промывания | Рекомендации и предосторожности |
|---|---|---|
| До 1 года | Только под наблюдением врача, капли в нос | Использовать только стерильный физиологический раствор. Исключить попадание жидкости в уши и глаза. После процедуры аккуратно удалить остатки жидкости. |
| 1-3 года | Спринцовка с мягким наконечником, капли в нос | Небольшое количество раствора, наклонить голову набок. Контролировать процесс, чтобы ребенок не подавился. После процедуры аккуратно удалить остатки жидкости. |
| 3-6 лет | Спринцовка с мягким наконечником, специальный чайничек для промывания носа | Объяснить ребенку процедуру, наклонить голову набок. Контролировать процесс, следить за дыханием. После процедуры аккуратно удалить остатки жидкости. |
| 6-12 лет | Специальный чайничек для промывания носа, небулайзер (с физиологическим раствором) | Самостоятельное промывание под присмотром взрослого. Правильное использование чайничка или небулайзера. После процедуры высморкаться. |
| >12 лет | Специальный чайничек для промывания носа, небулайзер (с физиологическим раствором), солевой раствор (только по рекомендации врача) | Самостоятельное промывание. Правильное использование приспособлений. При необходимости обратиться к врачу. |
Инструментарий
Как промывать нос ребенку при насморке в домашних условиях? Для введения лечебного раствора в носовые проходы можно использовать доступные в каждом доме инструменты. Однако перед их применением важно провести дезинфекцию, чтобы избежать попадания вредных микроорганизмов в мерцательный эпителий.
Для орошения носовой слизистой подойдут следующие инструменты:
- Пипетка — самый безопасный вариант для забора раствора, часто используемый для промывания носа у младенцев.
- Спринцовка — оснащена мягким или пластиковым наконечником, что делает введение раствора в носовую полость более комфортным.
- Шприц — используется для удаления жидкости из носа и введения лекарства под давлением поршня.
Выбор инструмента для ирригации носоглотки зависит от возраста ребенка. Для малышей до 1 года предпочтительнее использовать пипетки, а для детей старшего возраста можно применять спринцовки или нети-поты — специальные чайнички для орошения носоглотки.
Многие родители делятся своим опытом промывания носа детям в домашних условиях, и мнения по этому поводу часто расходятся. Некоторые утверждают, что это простая и эффективная процедура, которая помогает облегчить дыхание и снять заложенность. Они рекомендуют использовать солевые растворы, которые можно купить в аптеке или приготовить самостоятельно. Другие же предостерегают от самостоятельного промывания, особенно у маленьких детей, так как это может привести к неприятным последствиям, если не соблюдать осторожность. Важно помнить, что перед началом процедуры стоит проконсультироваться с педиатром, чтобы избежать осложнений. Многие родители отмечают, что регулярное промывание помогает предотвратить простуды и аллергические реакции, но ключевым моментом остается правильная техника и выбор средств.

Препараты
Терапевтический эффект процедуры зависит от эффективности препарата, используемого для орошения воспаленной слизистой оболочки. Чтобы избежать аллергических реакций, при лечении простуд у детей рекомендуется применять средства на основе физиологического раствора. Как можно промывать нос ребенку при насморке в домашних условиях?
- «Аква Марис» – стерильная изотоническая вода, содержащая макро- и микроэлементы, которые нормализуют работу мерцательного эпителия. Устраняет заложенность и воспаление в носовых проходах.
- «Долфин» – физиологический раствор с минеральными солями и растительными компонентами. Укрепляет местный иммунитет, восстанавливает секрецию слизи и ускоряет регенерацию тканей.
- «Фурацилин» – раствор с выраженными противомикробными свойствами. Подавляет активность как грамположительных, так и грамотрицательных бактерий, вызывающих гайморит, синусит и бактериальный ринит.
- «Мирамистин» – антисептическое средство, воздействующее на цитоплазматические мембраны патогенных микроорганизмов. Уничтожает большинство штаммов вредоносных бактерий, что помогает устранить гнойное воспаление в носоглотке и околоносовых пазухах.
- «Диоксидин» – антибиотик широкого спектра действия, который устраняет гнойно-инфекционные процессы в слизистой носа.
Антибактериальные препараты применяются исключительно для облегчения симптомов гнойных воспалений. Некоторые из них могут вызывать мутагенные изменения в наследственности, поэтому перед использованием любых лекарств рекомендуется проконсультироваться с педиатром.
Промывание пипеткой
Для облегчения носового дыхания у младенцев рекомендуется использовать пипетку для ирригации носа. Она обеспечивает мягкий поток жидкости, что помогает избежать попадания препарата в легкие малыша. При проведении этой процедуры следуйте нескольким ключевым советам:
- Перед началом промывания тщательно вымойте руки с антибактериальным мылом.
- Приподняв голову ребенка, аккуратно закапайте в каждую ноздрю по 3-4 капли лекарственного средства.
- Спустя минуту удалите накопившуюся слизь из носа с помощью шприца без иглы.
- Очистите носовые проходы ватными жгутами, смоченными в физиологическом растворе.
- Проводите ирригацию не менее трех раз в день.
Чтобы избежать пересыхания слизистой оболочки, установите увлажнитель воздуха рядом с кроваткой ребенка или смазывайте ноздри персиковым маслом после каждого промывания.

Промывание спринцовкой
Резиновая груша (или спринцовка) — многофункциональный инструмент, который чаще всего используется для орошения слизистых оболочек органов ЛОР. С её помощью можно не только промывать нос, но и очищать носовые проходы от накопившейся слизи. Важно помнить, что этот инструмент рекомендуется использовать только для лечения детей старше одного года.
Как правильно промыть нос ребенку в домашних условиях при насморке?
- Тщательно промойте спринцовку с мылом и теплой подсоленной водой.
- Наберите в грушу необходимое количество подогретого раствора.
- Наклоните голову ребенка в сторону.
- Вводите жидкость в верхнюю ноздрю, пока она не начнет вытекать из нижней.
- Изменив положение головы, повторите процесс для другой ноздри.
Важно! Во время процедуры попросите ребенка задержать дыхание на выдохе. В противном случае есть риск попадания раствора в ротоглотку.
При выраженном насморке орошение следует проводить не менее трех раз в день на протяжении недели. Если улучшения не наблюдается, рекомендуется обратиться к врачу. Высокая температура, увеличение лимфатических узлов и выделение слизи с гнойными примесями могут указывать на развитие синусита или гайморита.
Важные советы
Для достижения желаемых результатов в терапии при ирригации носа следует учитывать несколько ключевых моментов. Соблюдение этих рекомендаций поможет избавиться от неприятных симптомов простуды всего за несколько дней:
- Не проводите процедуру непосредственно перед сном, так как это может усилить выделение слизи под воздействием растворов.
- Если промывание носоглотки осуществляется в лечебных целях, выполняйте его не менее 7-10 дней подряд.
- После очищения носоглотки не выводите ребенка на улицу в течение 2 часов.
- Если врач назначает назальные капли или мази, применяйте их сразу после процедуры очищения носа.
- При спринцевании избегайте резкого нажатия на грушу.
- Для увлажнения слизистой носоглотки используйте небольшое количество растительных масел.
Чтобы удалить корочки в носу у новорожденных, промывайте нос отваром ромашки, разведенным с водой в соотношении 1:1. После размягчения корок аккуратно удаляйте их ватными турундами, смоченными в слабом солевом растворе или разбавленной перекиси водорода.
Вопрос-ответ
Как правильно промывать нос детям в домашних условиях?
Открыть рот и нажать на клапан, одновременно сделав не слишком глубокий вдох. Затем ту же процедуру проделать с другой половиной носа. Грудным детям процедура выполняется лежа, повернув голову набок. Промывать следует не более 2-3 раз в день.
Как промыть нос, чтобы вытекало из другой ноздри?
Наклоните Лейку, чтобы раствор поступал в носовой ход. При этом жидкость должна свободно вытекать из противоположной ноздри. Выпрямитесь и высморкайтесь. Повторите процедуру для другой ноздри.
Что лучше солевой раствор или физраствор?
Но главный фаворит: физраствор (единственный минус которого в удобстве применения) – дешево и сердито. Его можно закапывать из пипетки или без напора из маленького шприца. Гипертонические солевые растворы снимают отек слизистой, улучшают отток из пазух за счет высокой концентрации соли в полости носа.
Когда нельзя промывать нос солевым раствором?
В некоторых ситуациях следует воздержаться от этой процедуры: если в данный момент у вас диагностирован отит среднего уха или другой воспалительный процесс в ухе. При травме или искривлении носовой перегородки. Если вы недавно перенесли операцию в полости носа, следует обсудить возможность промывания носа с врачом.
Советы
СОВЕТ №1
Перед началом процедуры промывания носа убедитесь, что у ребенка нет противопоказаний, таких как сильная заложенность носа или аллергические реакции. Лучше всего проконсультироваться с педиатром, чтобы избежать возможных осложнений.
СОВЕТ №2
Используйте только стерильные и безопасные растворы для промывания, такие как физиологический раствор или специальные солевые растворы, которые можно приобрести в аптеке. Избегайте использования самодельных растворов, если вы не уверены в их безопасности.
СОВЕТ №3
Объясните ребенку, что будет происходить во время процедуры, чтобы он не испугался. Постарайтесь сделать процесс максимально комфортным и спокойным, возможно, предложив ему выбрать игрушку или книгу, чтобы отвлечь внимание.
СОВЕТ №4
После промывания носа дайте ребенку немного времени, чтобы он мог отдохнуть и восстановиться. Следите за его состоянием и при необходимости повторяйте процедуру, но не чаще 2-3 раз в день, чтобы не вызвать раздражение слизистой оболочки.